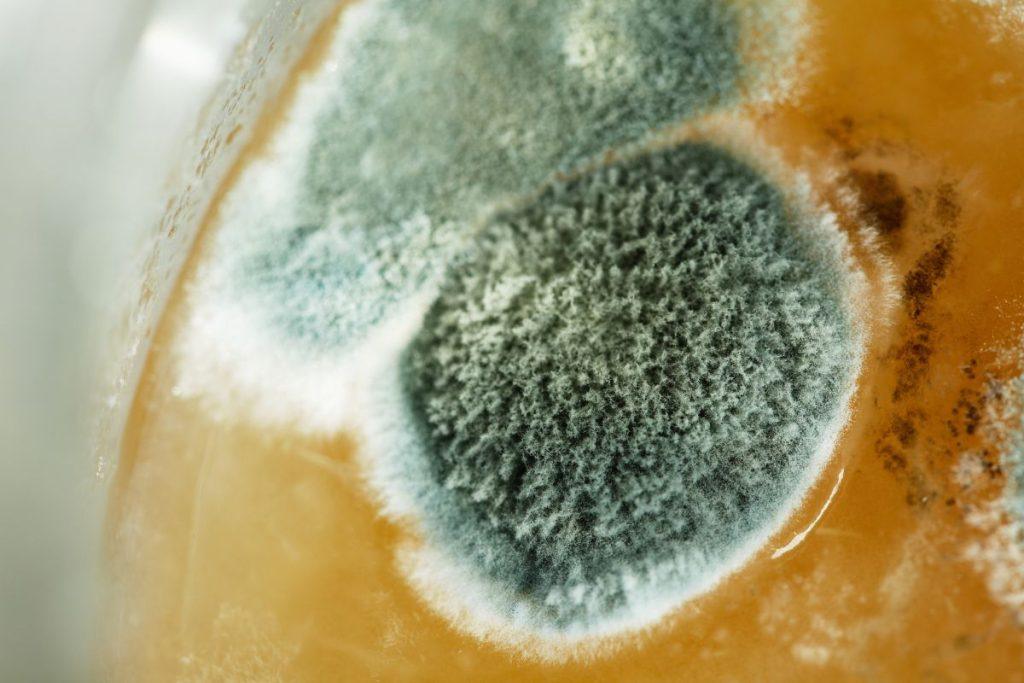

Daugeliui yra žinoma tokia situacija: atidarote duonos dėžę, o ten jūsų laukia nemaloni staigmena – pelėsis. Tarkime, tai tik keli maži taškeliai. Pusė žmonių išmes produktą iš principo, tačiau kita, atsargesnė pusė, paprasčiausiai nupjaus pažeistą vietą. Tačiau reikia žinoti, kad pelėsio sporos gali būti pasiskirsčiusios po visą maistą, net ir ten, kur vizualiai jo nematyti.
Šiandien mūsų redaktoriai atsakys į klausimą, kas nutiks, jei valgysite duoną su pelėsiu, ir kodėl reikia būti labai atsargiems – dažnai tai atsitinka netyčia. Be to, verta atkreipti dėmesį į tai, kad kai kurie pelėsiai gali gaminti mykotoksinus, kurie yra kancerogeniniai ir gali ilgainiui paveikti nervų sistemą bei hormonų balansą.
Apsinuodijimas pelėsiu
Pelėsis mėgsta šiltą ir drėgną aplinką, kurioje temperatūra siekia 20–30 °C, todėl tokios sąlygos tinka ne tik mums, bet ir šiam pavojingam grybui. Pelėsis gali nusėsti ne tik ant maisto, bet ir ant beveik bet kokio paviršiaus: gipso, popieriaus, betono, medžio, plastiko ir gumos. Ilgalaikis kontaktas su pelėsiu drėgnose patalpose gali sukelti rimtas kvėpavimo takų ligas, alergijas, astmos paūmėjimus ir net imunodeficito simptomus.
Kai pelėsis atsiranda ant duonos ar kitų maisto produktų, reikia žinoti, kad jį paprasčiausiai nupjauti nepakanka. Pelėsio sporos gali būti nepastebimos, o mikotoksinai prasiskverbia į visą gaminį. Nors vienas ar keli netyčiniai suvalgymo kartai dažniausiai nesukelia rimtų problemų, reguliariai vartojant supelijusį maistą, gali atsirasti rimtų sveikatos sutrikimų.
Pelėsio toksinai ir jų poveikis organizmui
Pelėsiai gamina toksiną, vadinamą mikotoksinu. Maži kiekiai paprastai filtruojami kepenyse ir nesukelia skausmo ar rimtų pasekmių. Tačiau dideliais kiekiais mikotoksinas gali sukelti:
- kepenų funkcijos sutrikimus, cirozę;
- imuninės, hormoninės ir nervų sistemos pažeidimus;
- kraujodaros procesų sutrikimus;
- ląstelių mutacijas ir galimą vėžio riziką.
Pirmieji apsinuodijimo simptomai gali būti galvos skausmas, pykinimas, bėganti nosis, bėrimai. Alergiškiems žmonėms rizika dar didesnė – gali atsirasti alerginis rinitas, edema ar net anafilaksinis šokas. Dauguma pelėsių rūšių yra nuodingos, o jų suvalgymas gali sukelti net opas skrandžio sienelėse.
Ką daryti, jei suvalgiau pelėsiu?
Jei valgėte maistą su pelėsiu, svarbiausia imtis veiksmų kuo greičiau:
- Paskubomis atlikite skrandžio plovimą.
- Vartokite absorbentus, pavyzdžiui, aktyvuotą anglį.
- Gerkite daug vandens, kad toksinai nesikauptų inkstuose ir kepenyse.
- Siekiant atstatyti žarnyno mikroflorą, gali būti skiriami priešgrybeliniai ir atstatomieji preparatai.
Be to, po apsinuodijimo rekomenduojama laikytis lengvos dietos, vengti alkoholio, riebaus maisto ir stengtis stiprinti organizmo imunitetą vitaminais bei mineralais.
Kodėl ant maisto atsiranda pelėsis?
Maisto produktai yra ideali grybelio buveinė. Dažniausiai pelėsis pastebimas ant duonos, pieno produktų, marinatų, konservų, o uogienėse pelėsis gali būti pašalinamas šaukštu. Pagrindinės priežastys – drėgmė namuose arba antisanitarinės sąlygos gamybos metu.
Siekiant apsisaugoti nuo pelėsio:
- reguliariai ir pakankamai šildykite patalpas;
- laikykite maistą sausoje, vėsioje vietoje;
- tikrinkite sunkiai pasiekiamas tamsias vietas, kur pelėsis gali atsirasti nepastebimai;
- informuokite šeimos narius apie pavojų.
Pelėsio kontrolė namuose taip pat apima drėgmės reguliavimą ir patalpų vėdinimą. Be to, verta atkreipti dėmesį į lentynėse ar spintelėse paliktus maisto produktus, kad jie nebūtų palikti ilgiau nei rekomenduojama.
Nuotraukos asociatyvinės © Canva.